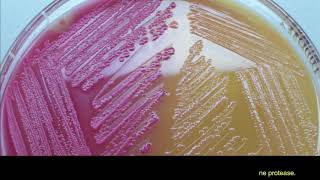

Shared 3 years ago
92 views
Shared 1 year ago
4 views
Shared 3 months ago
2.4K views
Shared 3 months ago
30 views
Shared 2 years ago
25 views
Shared 2 years ago
5 views
Shared 1 year ago
10 views
Shared 2 years ago
10 views
Shared 2 years ago
8 views
Shared 1 week ago
107 views
Shared 4 weeks ago
82 views
Uses of Enzymes in Industries| 9th Bio New Book| Lec # 4| Food & Paper Industry|Biological Detergent
Shared 8 months ago
401 views
Shared 2 years ago
189 views
Shared 2 years ago
130 views
Shared 4 months ago
9 views
Shared 3 weeks ago
35 views
Shared 11 months ago
216 views
Shared 3 weeks ago
8 views
Shared 9 months ago
176 views
Shared 7 months ago
23 views
Shared 10 months ago
1K views
Shared 4 weeks ago
22 views
Shared 5 years ago
215 views
Shared 1 year ago
227 views
Shared 3 months ago
9 views
Shared 5 years ago
45 views